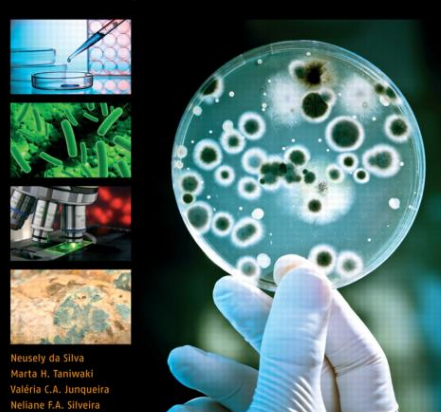
決定要測試自來水哪些參數

對于了解自來水檢測的人都知道,在所有的水質檢測方面它是最嚴格的,就那檢測項目來說日常的一些常規性就有9項,而周期性的檢測最多可達64項,因此要想保證這些水質參數的準確性就一定要掌握好方法,并對于每一個步驟都能夠熟練的操作,而今天我們就為大家介紹一些自來水檢測的方法?及具體的操作步驟中需要注意哪些問題?

你希望通過測試水質來完成什么?你想驗證飲用水源的安全嗎?收集有關已知污染的更多信息?
不同的答案會通知不同的測試策略,因為您要確保您收集的數據將有助于實現您的目標。比如如果想要知道自來水水質檢測的準確結果,就必須要借助專業的水質檢測儀,具體的細節請咨詢水質專家,以獲取自來水的檢測方法及建議,以及如何準確地獲得這些信息。
對資金和獲取分析服務的限制使得對各種可能類型的污染進行水樣測試是不切實際的。相反您將需要選擇與您的計劃目標最相關的測試。

對于自來水的參數來說有很多種檢測方法。不過我們在使用水質檢測儀時一定要考慮每個選項的精確度和檢測限制(即它是否能準確地區分百萬分之四十和百萬分之五十之間的污染物,或者僅僅是十和百分之一?可以檢測到百萬分之0.1以上的水平,或者僅高于百萬分之一)
一般而言一些特定測試程序在數據精確方面會有所誤差。例如DIY領域的試劑盒可用于許多測試,但與水質檢測儀相比可靠性和結果精確度要低很多。

在確定自來水水質檢測方法后,要將其歸納成一整套的計劃,包括自來水樣品采集時間等。
除了自來水樣本收集和分析之外,還要考慮是否需要收集額外的數據以實現檢測目標。比如可能包括當地衛生診所提供的有關水痘發病率的信息,或者社區成員關于他們對水質和相關健康問題的看法的報告。
在測試過程中保持一致的記錄可能是一個挑戰 - 也許最好的方法是為收集的每個樣本開發標準化的信息表。除了為每個采樣點記錄GPS坐標之外,還應該拍攝可能影響水質的天氣條件(如雨水)的來源和記錄信息。

一般來說仔細閱讀特定于您的測試設備和耗材的說明是必要的。另外還有一些一般的指導原則:
由于很容易將污染物引入樣品中或樣品之間,因此維持無菌的工作環境至關重要。請注意在處理環境樣品時,盡肯能戴上手套,并在使用前后對自來水檢測儀器進行消毒。如果您無法進入指定的實驗室區域,可以使用鋁箔或塑料薄膜來創建一個易于清潔的平整工作表面。
小玻璃或金屬設備可以通過與燃氣打火機或火爐的明火接觸進行滅菌(其他火焰會導致煙灰積聚)。金屬和耐熱塑料也可以通過在沸水中浸泡15分鐘來消毒。請注意對于消毒設備來說,漂白劑通常是一個不好的選擇,因為它傾向于留下殘留物,除非設備用無菌水徹底漂洗(但對于清潔您的工作區域也是有用的)。
在樣品采樣時通常應該在采集之前用水沖洗幾分鐘以沖洗系統。
應收集足夠的水量,以便根據計劃檢測不同的自來水參數,或操作失誤時能進行重復測定。不過至少要收集100毫升用于微生物檢測。
一旦收集樣品應保持冷卻(如果可能的話,在冰上)并在24小時內處理,以最小化分析前細菌生長或死亡的程度改變水質。收集后超過30小時的樣品不應進行測試。
在您的測試計劃中,通常需要包括協議來解決這些考慮事項,以確保不同水質樣品之間的一致性,特別是如果抽樣是由多人進行的話。
這里的細節將取決于你選擇的方法的性質,但一些一般的做法是廣泛適用的。例如使用已知濃度的目標物質分析對照樣品以驗證測試方法的準確性,作為質量控制實踐通常是必要的。或者樣品的一部分(例如1/20)可以一式兩份或一式三份測試,以能夠對結果進行比較。通過有/無微生物檢測,通常使用無菌水的空白樣品作為對照。
如果您在任何時候分割樣品,請預先用力搖動10秒鐘。沉積物和微生物等較大的水分成分會隨著時間的推移而沉降,需要重新混合以確保子樣品代表整體。
當一個特定的測試能夠檢測到比環境中可能存在的更小的濃度范圍時,可以對自來水樣品進行稀釋。比如量化樣品中活的大腸桿菌的數量的測試可以可靠地檢測到100mL樣品中10至100個細菌的濃度,但是可能的環境濃度范圍為每100mL 100至1000個細菌,稀釋度為10 mL的樣品在90mL無菌水中(10-1稀釋)。當環境濃度未知時,同時測試一系列稀釋度可以增加至少一個可用結果返回的可能性。

鑒于在抽樣和分析過程中引入誤差的潛在途徑的數量,水質結果要謹慎解讀。重要的結果(例如發現意外污染或風險水源的明顯安全性)應在采取行動之前通過復制進行驗證(理想情況下,您的測試計劃將解決此問題)。
只有在持續測試歷史記錄與季節變化相一致(例如,在雨季期間生產安全用水的地表春季可能在雨季期間受到徑流污染)之前,水源不應被視為安全。如果在當地公布結果,請仔細考慮您的方法,因為細微的調查結果可能很難與沒有技術背景的聽眾溝通。
上一篇:魚塘水質快速檢測儀什么價格
下一篇:COD水質檢測儀價格詳情